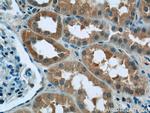
RPGR Antibody in Immunohistochemistry (Paraffin) (IHC (P))

Search
Proteintech
RPGR Polyclonal Antibody
{{$productOrderCtrl.translations['antibody.pdp.commerceCard.promotion.promotions']}}
{{$productOrderCtrl.translations['antibody.pdp.commerceCard.promotion.viewpromo']}}
{{$productOrderCtrl.translations['antibody.pdp.commerceCard.promotion.promocode']}}: {{promo.promoCode}} {{promo.promoTitle}} {{promo.promoDescription}}. {{$productOrderCtrl.translations['antibody.pdp.commerceCard.promotion.learnmore']}}
产品信息
16891-1-AP
种属反应
宿主/亚型
分类
类型
抗原
偶联物
形式
浓度
规格
纯化类型
保存液
内含物
保存条件
运输条件
产品详细信息
This antibody can recognize all the isoforms of RPGR.
Immunogen sequence: MREPEELMP DSGAVFTFGK SKFAENNPGK FWFKNDVPVH LSCGDEHSAV VTGNNKLYMF GSNNWGQLGL GSKSAISKPT CVKALKPEKV KLAACGRNHT LVSTEGGNVY ATGGNNEGQL GLGDTEERNT FHVISFFTSE HKIKQLSAGS NTSAALTEDG RLFMWGDNSE GQIGLKNVSN VCVPQQVTIG KPVSWISCGY YHSAFVTTDG ELYVFGEPEN GKLGLPNQLL GNHRTPQLVS EIPEKVIQVA CGGEHTVVLT ENAVYTFGLG QFGQLGLGTF LFETSEPKVI ENIRDQTISY ISCGENHTAL ITDIGLMYTF GDGRHGKLGL GLENFTNHFI PTLCSNFLRF IVKLVACGGC (1-359 aa encoded by BC031624)
靶标信息
This gene encodes a protein with a series of six RCC1-like domains (RLDs), characteristic of the highly conserved guanine nucleotide exchange factors. The encoded protein is found in the Golgi body and interacts with RPGRIP1. This protein localizes to the outer segment of rod photoreceptors and is essential for their viability. Mutations in this gene have been associated with X-linked retinitis pigmentosa (XLRP). Multiple alternatively spliced transcript variants that encode different isoforms of this gene have been reported, but the full-length natures of only some have been determined.
仅用于科研。不用于诊断过程。未经明确授权不得转售。
生物信息学
蛋白别名: mRpgr; retinitis pigmentosa 15; retinitis pigmentosa 3 GTPase regulator; unnamed protein product; X-linked retinitis pigmentosa GTPase regulator; XLRP3
基因别名: COD1; CORDX1; CRD; orf15; PCDX; RP15; RP3; Rp3h; RPGR; XLRP3
UniProt ID: (Human) Q92834, (Mouse) Q9R0X5
Entrez Gene ID: (Human) 6103, (Mouse) 19893